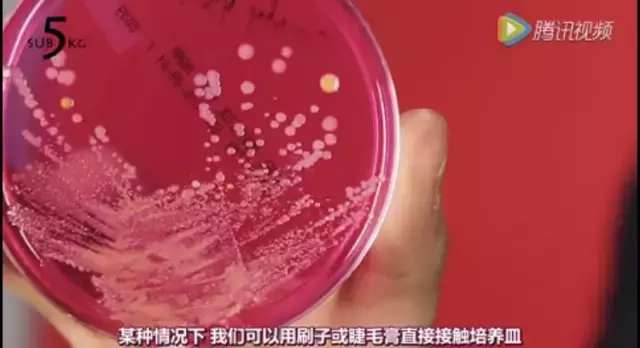
化妆刷怎么消毒,化妆刷清理教程
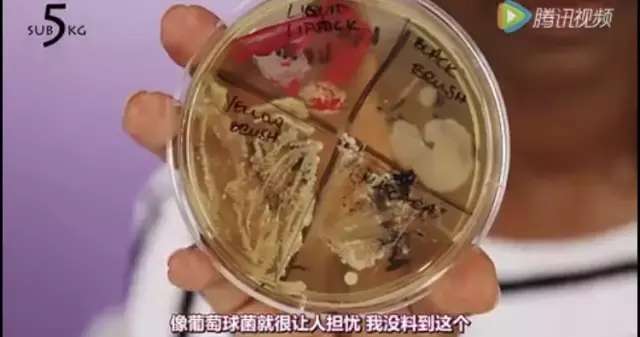
化妆刷怎么消毒,化妆刷清理教程
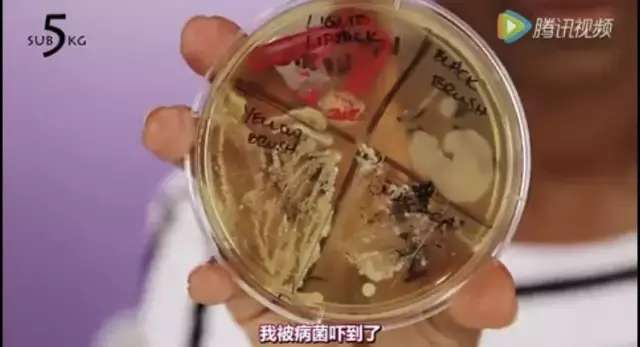
化妆刷怎么消毒,化妆刷清理教程

最近乱揉眼睛 把眼睛搞发炎了
分分钟觉得有东西在眼睛里糊着
但除了滴点眼药水也拿它没办法
简直抓狂到原地爆炸
氮素 小仙女们 你们有没有想过
你们的化妆品化妆刷可能也是造成眼睛发炎皮肤发炎的凶手呢?
今天给你们开开眼☟

本次实验找了三个妹子来做测评
姑且就叫他们
丸子头 波浪卷 齐刘海吧

以下为依次发言





波浪卷说出了小仙女们的的心声吧




齐刘海妹子
控制住制几好么



看起来很腻害的大叔上线科普

脑膜炎啊旁友们
此处应该有10000+个震惊脸











莫名觉得齐刘海妹子萌萌哒~
以下是丸子头
哦不 人家换了发型
应该是马尾辫
的实验结果☟

虽然波浪卷的是最好的了
可我看着那个培养皿
还是觉得方方的
so
小仙女们内心的OS是什么?
哎哎哎
我的宝贝化妆品们
你们都遭遇了什么
我想选择狗带
心疼的抱住你们
所以除了定期丢掉开封已久的睫毛膏唇釉等等
虽然我知道你舍不得
但是为了你的脸,答应我不要放太久好么
(一脸真诚)
来说一说化妆刷的清洁吧
多久洗一次?
刷子类尽量每周清洗并且换的勤快一点
反正你们都喜新厌旧不是么
美妆蛋 海绵粉扑之类的2-3天最好洗一次
怎么洗?

step1
准备好要洗的脏刷子

step2
用温水打湿 最好是用流动的水 就是水龙头的那种

step3
将刷子洗剂倒在手心
用刷子在手心里画圈
让刷毛充分沾满洗剂

step4
用温水冲掉化妆品混合洗剂脏兮兮的东西

step5
重复以上过程
直到水流变清

step6
用手指将多余的水分挤压走

step7
平放在干净的毛巾,纸巾上风干
PS:
注意不要用吹风机
也不要拿到太阳下晒
更不要倒着放。
不然很容易炸毛和损伤刷子。
平方自然阴干就好。
千万不要用卸妆油卸妆液之类的洗刷子
最好买专用的洗剂
实在不行用婴儿洗发水也可以。
觉得这样洗不干净的
也可以把洗剂倒到小瓶盖里
用洗剂:水为3:7的比例浸泡清洗
像这样

注意不要把整个笔都泡进去
接口处一般都是胶水连接
很容易把笔给泡成两截
别问我知怎么知道的。

最后
给大家分享一些洗刷子的小玩意儿
比如下图这种硅胶的清洗垫
类似的东西万能的淘宝都找得到。

还有个这
噔噔噔噔~
stylpro的洗刷器
黑科技拯救懒癌系列
(国内无法购买,有兴趣的小仙女可以代购试试:)


GIF
将电动刷杆和刷子套在一起
在洗刷碗里放入洗剂
将刷子充分的沾湿

开启涮刷子模式
可以看到刷子上残留的粉底液和洗剂混合后的颜色
(强迫症觉得很爽啊:)

GIF
觉得涮的差不多之后把刷子向上提进行甩干
(也很爽啊有木有)
20秒后你就能获得一把干净的刷子了
当然
鉴于这货比较难买
我还有另一个东西给你们看
小仙女们 Are you ready
就是它

叫化妆刷清洁海绵吧好像
是我找资料的时候无意发现的
感觉很神奇的样子

欢迎用过的小仙女后台留言反馈啊
好用的话我也去买一下
今天的推送到此结束
爱你们o~